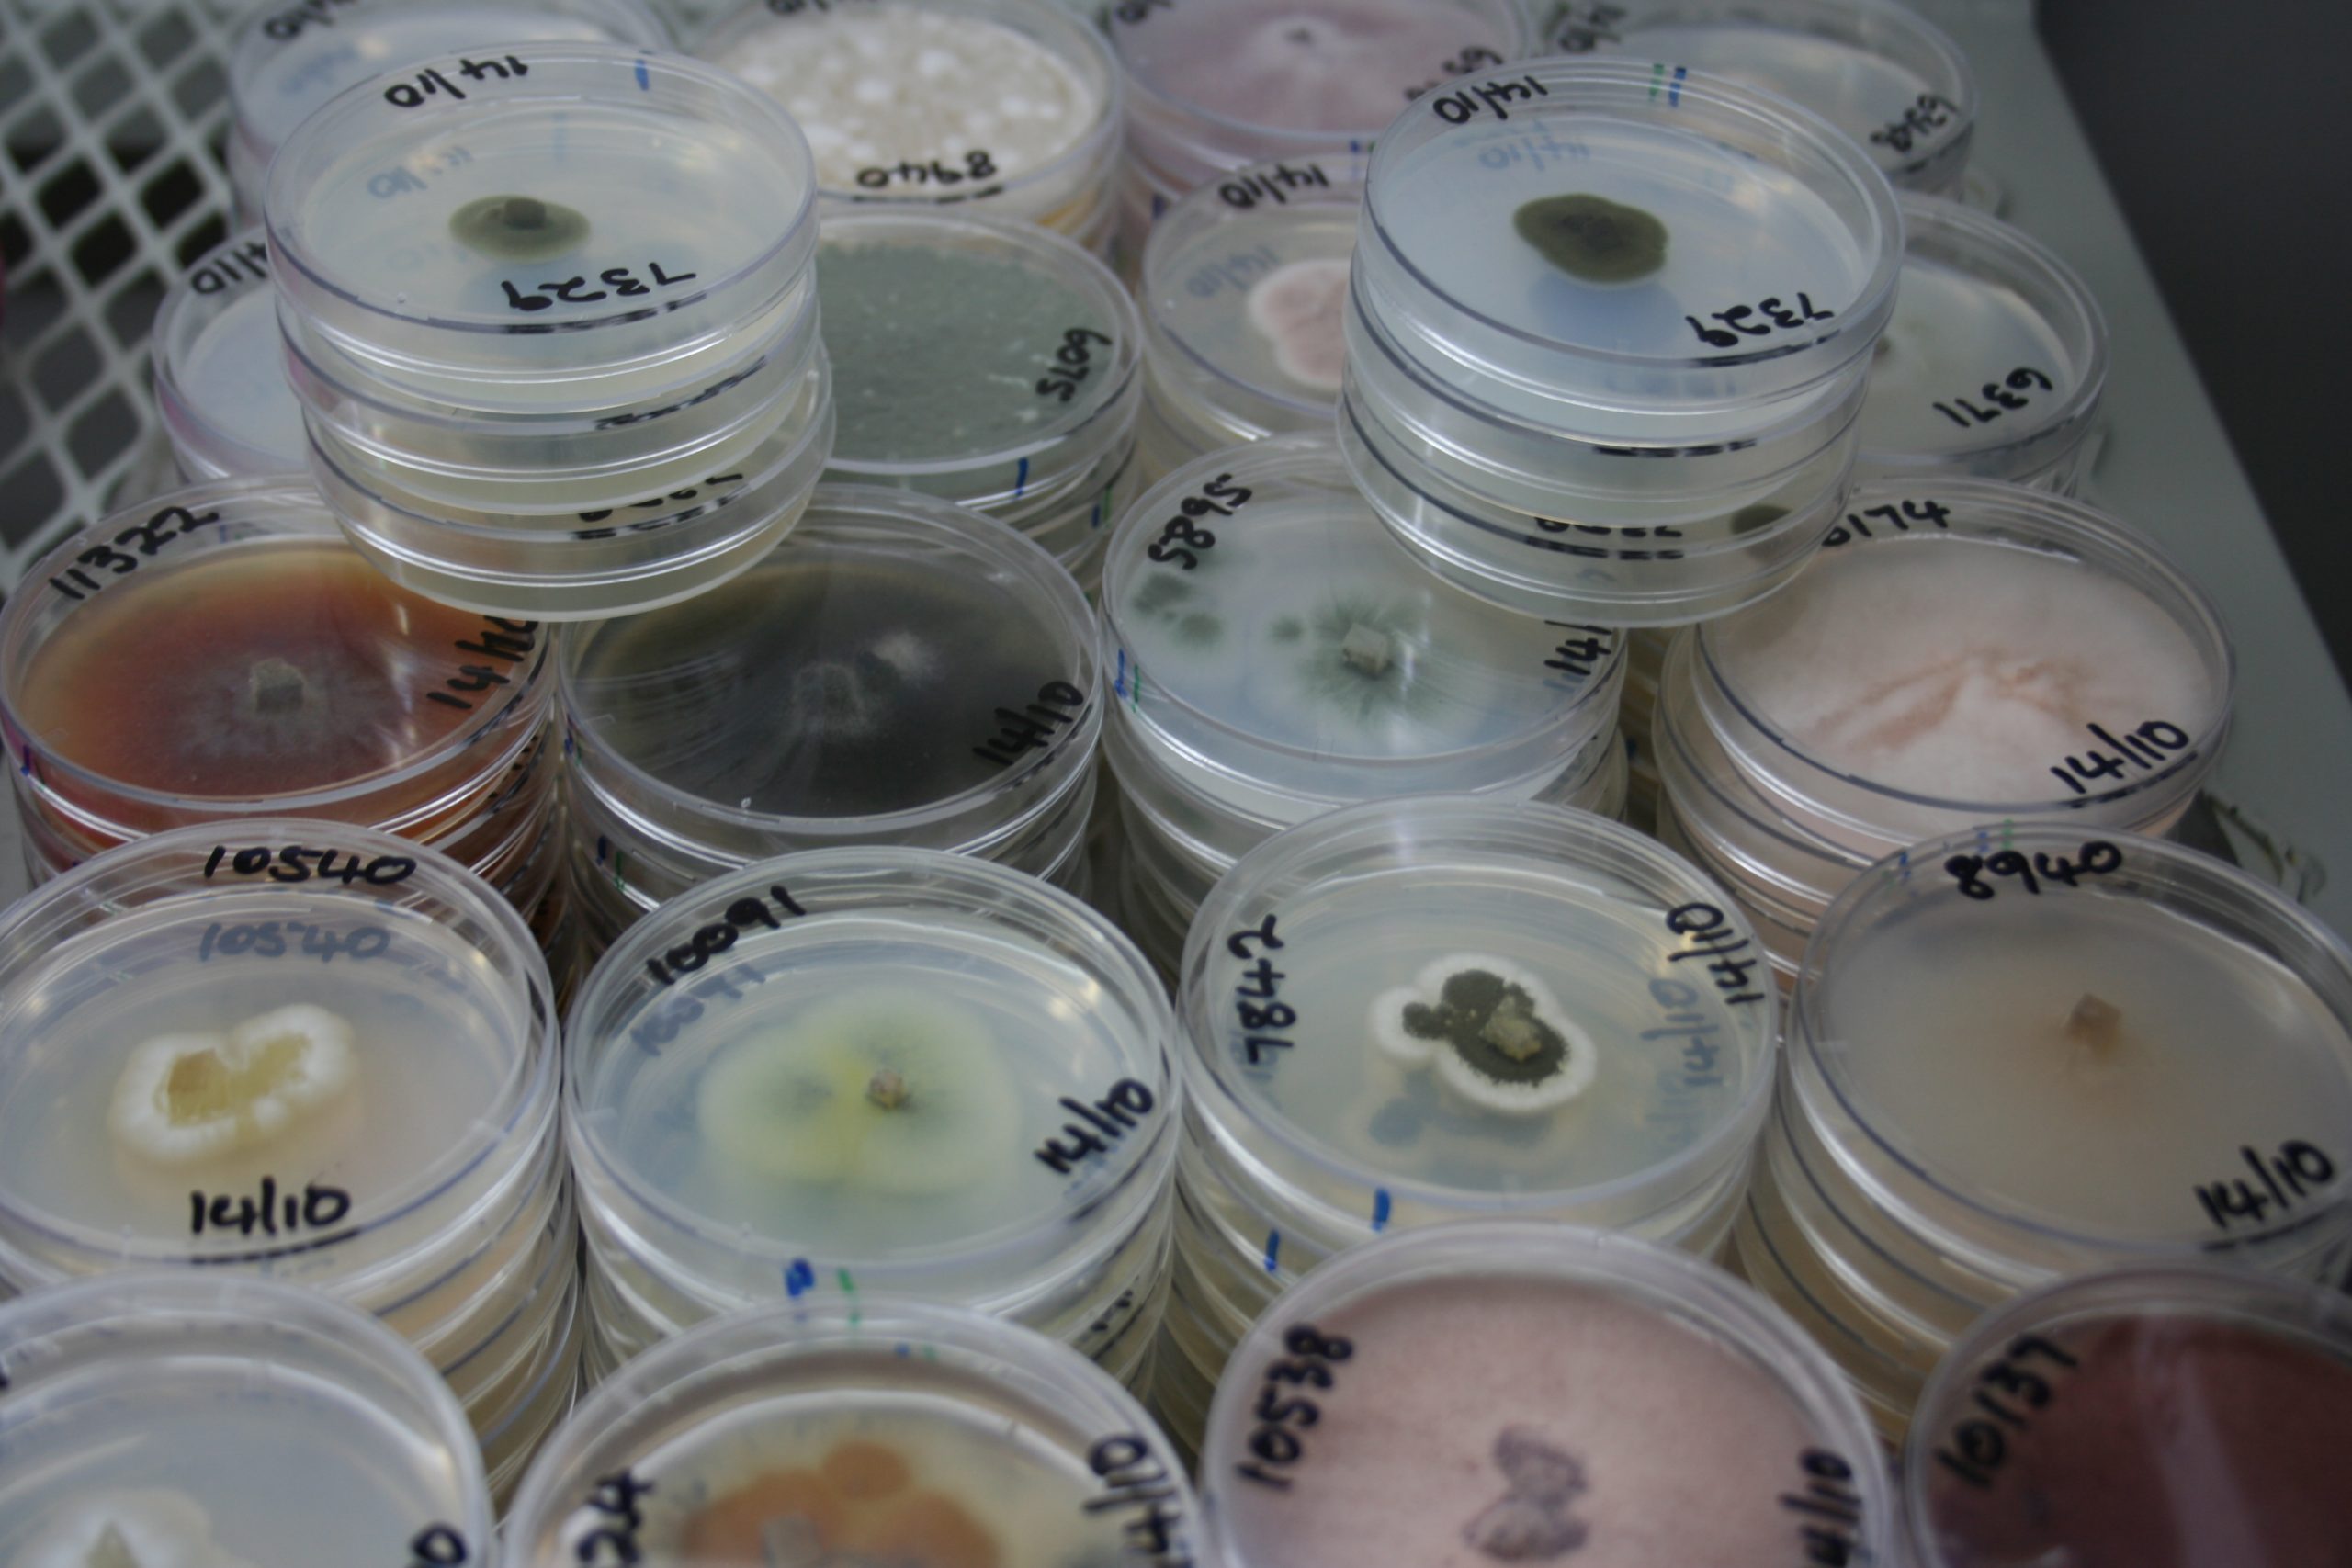
ARC Invasive Fungal Hub Collections

Invasive Fungi Hub At ARC-PHP: Coming Together To Protect SA’s Food Security
Worldwide, invasive species are recognized as a threat to biosecurity and food security. According to one global estimate, the cost of invasive species amounts to more than US$300 billion per year. But the impact of invasive fungi are less well-understood, and harder to quantify.

Dr Adriaana Jacobs, Curator of the National Collection of Fungi and Senior Researcher at the ARC’s Plant Health & Protection unit.
“Understanding the scale of impacts of invasive species would be a first step towards estimating their costs – and then mitigating them,”explains Dr Adriaana Jacobs, Curator of the National Collection of Fungi and Senior Researcher at the ARC’s Plant Protection Research Institute. “But impacts have in most cases been poorly quantified – and that’s particularly true when it comes to invasive fungi.”
The Agricultural Research Council’s newly-launched Invasive Fungi Hub (IFH) will amalgamate existing data and expertise across South Africa to better understand the threat posed by invasive fungi – and help provide biosecurity to ensure farmer profitability and food security.
Established in 1905, the National Collection of Fungi, better known by the international acronym PREM (PRE for Pretoria, where it’s situated, and M defining the collection as being mycological), houses approximately 63 000 specimens of fungi from all over the world. The PPRI (acronym registered with World Federation of Culture Collections) living collection at the Plant Health & Protection campus also has 33 000 strains, and is part of the Biodiversity Biobanks South Africa (BBSA), which provides a coordinating structure across several of South Africa’s existing biodiversity biobanks.
Globally, there are many examples where plant pathogens were introduced and became established, resulting in a threat to a specific host – such as Phytophthora ramorum and Phakopsora pachyrhizi, which cause an estimated loss of $21 billion per year.

Fusarium Wilt TR4; banana cultivar with yellowing symptoms on lower leaves. ©David Jones from https://www.cabi.org/isc/datasheet/24621
On the African continent, the spread of Fusarium oxysporum f sp. cubense (better known as Banana Wilt) by means of anthropogenic activities, including the movement of infected plant material, water and soil, has had a devastating effect on regional economies.
And examples from South Africa include: 9 pathogenic species known to attack indigenous plants; 11 saprotrophic species; 23 host-specific pathogens of listed alien terrestrial plants; 61 ectomycorrhizal species; and 7 host-specific pathogens deliberately introduced as biological control agents.
There is a lot that is still unknown, though.
“Despite the increasing knowledge of the impact of invasive alien species, most information is based on studies conducted in developed countries – and they frequently do not take into account the impact on small scale farming,” Dr Jacobs notes.
Smallholder farmers in sub-Saharan African countries represent 80% of all farmland (approximately 33 million farms) and produce most of the crops. Part of the IFH’s aims will be to determine the impact of invasive fungi in the South Africa and SADC crops framework.
“We want to mobilise and expand existing platforms to support government in their effort to ensure food security in South Africa,” Dr Jacobs notes.
How Do We Fight Invasive Fungi?
There are various means by which introductions of invasive species could take place. These include natural pathways, international trade and other anthropogenic activities.
“Overall, exotic invasions increase with time, mainly due to globalisation,” Dr Jacobs notes. “Invasions by fungi are no exception, and the movement of live plants – and humans – is known to be an important pathway for invasive plant pathogens to enter new territory.”

International travel can spread invasive fungi.
Worldwide, legislation and regulations have been implemented to try to reduce the risk of new introductions and in most countries these are based on international treaties and conventions – like South Africa’s Perishable Products Export Control Act (PPEC Act), No 9, of 1983, mandating the Department of Agriculture, Land Reform and Rural development (DALRRD) to deliver end-point inspection services on perishable products destined for export.
They help, of course – but due to the sheer volume and lack of inspection personnel devoted to this process only a relatively small percentage of imports are physically inspected.
So when threats materialise, National Public Goods Assets (NPGAs) or National Collections need to be prepared.
“It’s too late to seek reference material from collaborators during an incursion,” Dr Jacobs explains. “When invasive fungi are detected, there should be no uncertainty over where to source material and find the independence required to eliminate potential conflicts involving vested interests.”
IFH: Coordinating Knowledge, Combating Crises

The ARC Invasive Fungi Hub houses several collections.
The ARC’s Invasive Fungi Hub will amalgamate existing data and expertise across the country under the lead of the National Collection of Fungi to support the biosecurity mandate of DALRRD with sound scientific gap analyses and directed research focuses.
“Although NPGAs can have some input into estimating biosecurity risks, by-and-large risk analysis is another domain and not part of a collections’ strategy,” Dr Jacobsnotes. “The IFH will allow us to coordinate information so we know what we’re dealing with, where it’s distributed historically, and help custodians of collections be aware of the species of plant health concern, and changes in the species of concern that stem from changing trade patterns, crops or farming practices.”
Collections custodians and researchers have an important role to play by:
- Reporting new reports via the correct government structures and regulations
- Depositing material for long term reference material in the National Public Good Assets
- Ensuring sufficient material for accurate identifications with the latest recognised techniques
- Making material available for study
- Supporting research nationally, regional and globally
- Providing baseline data for biodiversity conservation
- Facilitating the bioprospecting drive
As an initiative to expand this support base the fungal-based NPGA at the ARC has embarked on an initiative aimed at expanding the current knowledge basis on which stakeholders such as DALLRD, DSI and DFFE can base sound decision-making regarding invasive fungi.
But it’s not just up to researchers.
“It is all the people of South Africa’s responsibility to protect our biodiversity and food security against invasive fungi. We all have a part to play.”
Want to know more about the National Collection of Fungi? Visit https://www.arc.agric.za/arc-ppri/Pages/Biosystematics/Mycology%20Unit%20(Fungi)/Mycology-National-Collection-of-Fungi.aspx – or contact Dr Adriaana Jacobs at JacobsR@agric.ac.za.

What are biodiversity biobanks?
Biodiversity biobanks are repositories of biologically relevant resources, including reproductive tissues such as seeds, eggs and sperm, other tissues including blood, DNA extracts, microbial cultures (active and dormant), and environmental samples containing biological communities….